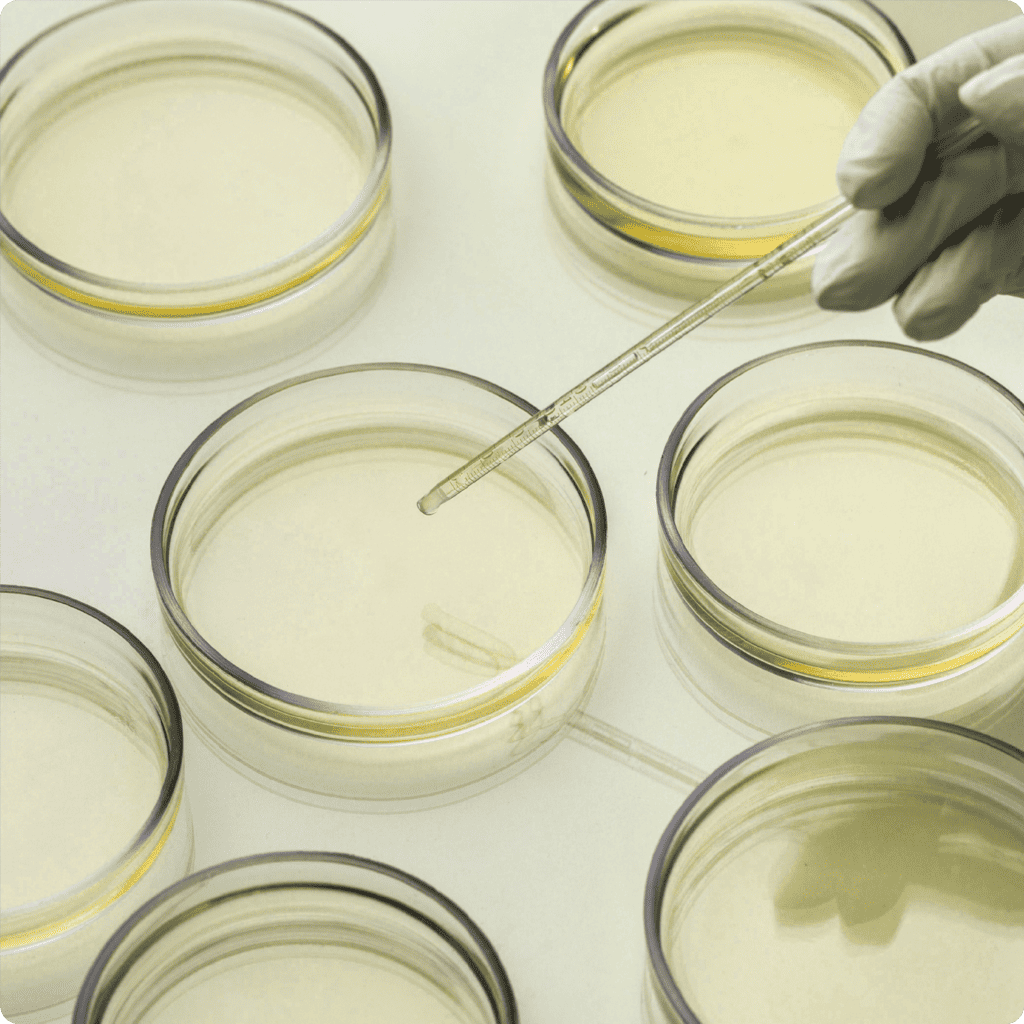

A pioneer in the application of phage technology, ensuring the sustainable production of safe foods from farm to fork, promoting the holistic concept of one health, and actively combating the global challenge of antimicrobial resistance (AMR).









We strive exchange knowledge and ideas across the phage-related space to further explore the fundamental aspects of phage including their genetic diversity, phages-hosts relationships, phage-driven microbiome, and to enhance the application of phages through innovation.
UniFAHS welcomes students and researchers to join our team to work together to achieve these goals.
To be Global Partnership in Phage area to complete the global mission.
such as Salmonella, E. coli, Listeria, and Vibrio
Which are linked to contamination in primary production and food processing and the cause of serious foodborne illnesses worldwide. Our collection also contains phages that can infect and kill antimicrobial resistance (AMR) bacteria such as Staphylococcus, Pseudomonas, and Acinetobacter baumannii. Working in collaboration with veterinarians and specialists within the poultry, dairy, aquaculture and feed sectors, we have extended the application of our phages to food-producing terrestrial animals (poultry, swine and dairy cattle), to shrimps and fish, and to animal feeds.
Since our expertise covers all aspects of the phage technology, we are capable of customizing our phage offering to meet the specific needs of each sector.
The use of phages in animal health aligns with the “One Health” approach, recognizing the interconnectedness of human, animal, and environmental health. By promoting the well-being of animals, phages contribute to overall ecosystem health and the sustainable management of animal populations.
Phages can play a role in promoting the growth and balance of beneficial bacteria in the gut microbiome of animals. By selectively targeting harmful bacteria, phages indirectly create a favorable environment for the proliferation of beneficial bacteria.
Phages can play a significant role in ensuring food safety and quality by maintaining the sensory qualities of the food we consume. Application Phages can be applied to various stages of the food production process, including raw materials, processing, storage, and packaging.
One of the major foodborne illness and AMR case is caused by Salmonella outbreaks worldwide to send you to the hospital from food in each year
Estimated global cost of foodborne illnesses caused by Salmonella
World’s Leading
Salmonella Hunter
PhagePrompt SalmoGuard MEATTM is Salmonella hunter for meat production
The benefit of PhagePrompt SalmoGuard MeatTTM
The Phage hero has arrived, to fight Salmonella spp.
The benefit of PhagePrompt SalmoGuard MeatTTM
Combats Salmonella spp. linked to meat processing
Food Quality
Keeps the nutritional value of food, taste, color, odor and overall appearance as original products.
Eco-Friendly
Friendly & Safe for ALL (Human, Equipment and Environment)
UniFAHS’ ultimate goals are to reduce the incidence of AMR and promote food safety and sustainability by applying effective bacteriophage formulation to control bacterial contamination along the food supply chain to minimize the use of antibiotic or chemical treatments.
UniFAHS‘ lab also works under One Health’s approach in which we have worked under collaborative efforts of multiple disciplines working locally, nationally, and globally, to attain optimal health for people, animals and our environment. We strongly believe the meaningful and the power of One Health that can sustainably balance and optimize the health of people, animals, and ecosystems. We work towards the protection of emerging of infectious diseases and antimicrobial resistance.
UniFAHS’s IP assets consist of a unique combination of patents and trade secrets.

Food safety contributes by PhagePromptTM

Livestock

Aquaculture

Food Products
Excellent customer experience
Reducing Antibiotic Use
Positive environmental impact contribution
Reducing GHG
Committed to net-zero emissions by 2030
Renewable Electricity by 2030
Net Zero Emission by 2050
Net Positive Impact on Food & Agriculture by 2050 Renewable Energy & Improvement Sustainable Transportation Waste Management
Accelerate the development of New CO2 – Free Processes for the Production of Phages by 2028.
Carbon Footprint Assessments Service Measure to lower GHG > 50% by 2050
Reduce AMR cases > 20% by 2050
Reduce > 45% of Chemical Concentration in Water and Farm Land
Effective governance standards across UniFAHS entities
100% of strategic suppliers implementing their own code of conduct
Collaboration for positives ESG impact
Dr. Kitiya Vongkamjan,
Ph.D. (Cornell Univ, New York)
Founder & CEO
Over 15 years in Phage R&D
Opal Chalita Wongpukdee,
B.Sc. (Prince of Songkla Univ, Thailand)
Co-Founder & CMO
Over 10 years in Agri-Business
Dr. Vincent Guyonnet,
DVM, Ph.D, Dipl. ACPV
Director of Business Development
Over 40 years in the Livestock Industry
Dr. Mingkwan Yingkajorn,
MT, Ph.D. (Fulbright, Harvard Univ)
Director of Technology &
Application Transfer
Over 15 years in AMR Solutions
Dr. Tom Aurand,
Ph.D.
Over 40 years,
Ex-R&D Director, Land O’Lakes,
USA International consultant
– Food & Feed industry
Dr. Chin How-Cheong,
Over 40 years, Poultry &
Veterinary Consultant
Ex-Senior Executive VP (Technical),
JAPFA International, Singapore
Dr. Ruttayaporn Ngasaman,
Over 15 years, Veterinary Public
Health / One Health